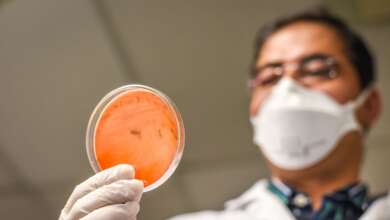

Laboratoire
- Actu Santé
 Défi Santé13 March 2026
Défi Santé13 March 2026Analyse du sperme à Maurice : C-Lab met en avant son LensHooke X3, un analyseur optique de la qualité du sperme
Une innovation pionnière dans l’évaluation de la fertilité masculine à Maurice. En effet, C-Lab a récemment effectué l’acquisition du LensHooke…
À Lire » - Actu Santé
 Défi Santé7 May 2024
Défi Santé7 May 2024C-Lab : un 24e centre de prélèvement voit le jour à Forest-Side
C-Lab poursuit son expansion à travers le pays et se rapproche de sa patientèle des hauts ! Le laboratoire du…
À Lire » - Actu Santé
Défi Santé22 June 2023
Défi Santé22 June 2023Programme SANOI : La sécurité alimentaire et nutritionnelle au cœur d’un atelier régional
Pendant trois jours, les laborantins mauriciens et ceux de la région se sont réuni à l’hôtel Le Labourdonnais Waterfront à…
À Lire » - Actu Santé
 Défi Santé31 January 2023
Défi Santé31 January 2023« Routine check up » : nouveaux packages bilan de santé lancés par Life Nova +
Tous les jours, notre bien-être et notre santé sont impactés par nos modes de vie : alimentation, transports, stress, sédentarité,…
À Lire » - Actu Santé
 Défi Santé29 April 2022
Défi Santé29 April 2022C-Lab : Un roadshow prévu ce samedi 30 avril pour sensibiliser aux tests génétiques
C-Lab organise un roadshow dans les cinq principaux centres commerciaux de l’île afin de promouvoir l’importance des tests génétiques. Cet…
À Lire » - Actu Santé
 Défi Santé10 November 2021
Défi Santé10 November 2021Laboratoire : un 10e point de collecte de C-Lab ouvert à Rose Belle
Se rapprocher des clients pour mieux les servir est essentiel pour C-Care ! Le groupe de santé, fidèle à ses…
À Lire » - Actu Santé
 Défi Santé18 August 2021
Défi Santé18 August 2021Le Brown Sequard Mental Health Care Centre va gérer son propre laboratoire d’analyse
Le ministre de la Santé et du Bien-être, le Dr Kailesh Jagutpal, a inauguré le mardi 17 août un nouveau…
À Lire » - Actu Santé
 Fateema Capery17 December 2020
Fateema Capery17 December 2020C-Lab inaugure un nouveau point de collecte à Port-Louis
C-Lab a ouvert son 9e point de collecte à travers l’île. Située à la rue Virgil Naz, à Port-Louis, cette…
À Lire » - Actu Santé
 Fateema Capery9 December 2020
Fateema Capery9 December 2020Laboratoire médical : C-Lab étend son réseau à Port-Louis
Fort de ses 75 ans d’expérience combinée dans le domaine médical, C-Care (Mauritius) Ltd renforce son développement en ligne avec…
À Lire » - Actu Santé
 Défi Santé25 August 2020
Défi Santé25 August 2020Laboratoire médical : C-Lab inaugure un point de collecte à Flacq
C-Lab a ouvert son huitième point de collecte à Flacq. Cette filiale de C-Care (Mauritius) Ltd, spécialisée en matière d’analyses…
À Lire »
